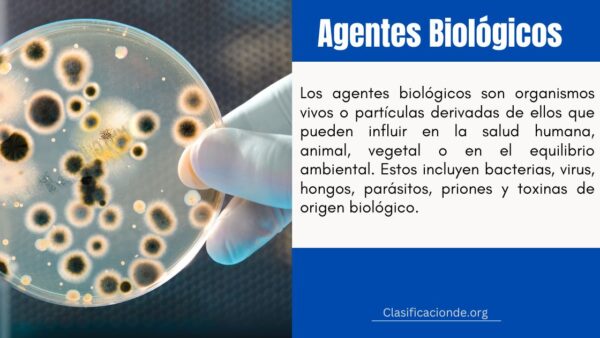
Agentes Biológicos

7 Ejemplos de Energía Electromagnética
Imagina un mundo sin luz, sin calor del sol, sin radio, sin teléfonos móviles, sin rayos X en los hospitales. Este mundo sería imposible sin una forma de energía fundamental y ubicua: la energía electromagnética. Es la fuerza invisible que impulsa gran parte de nuestra existencia moderna y los procesos naturales del universo. Desde el calor […]